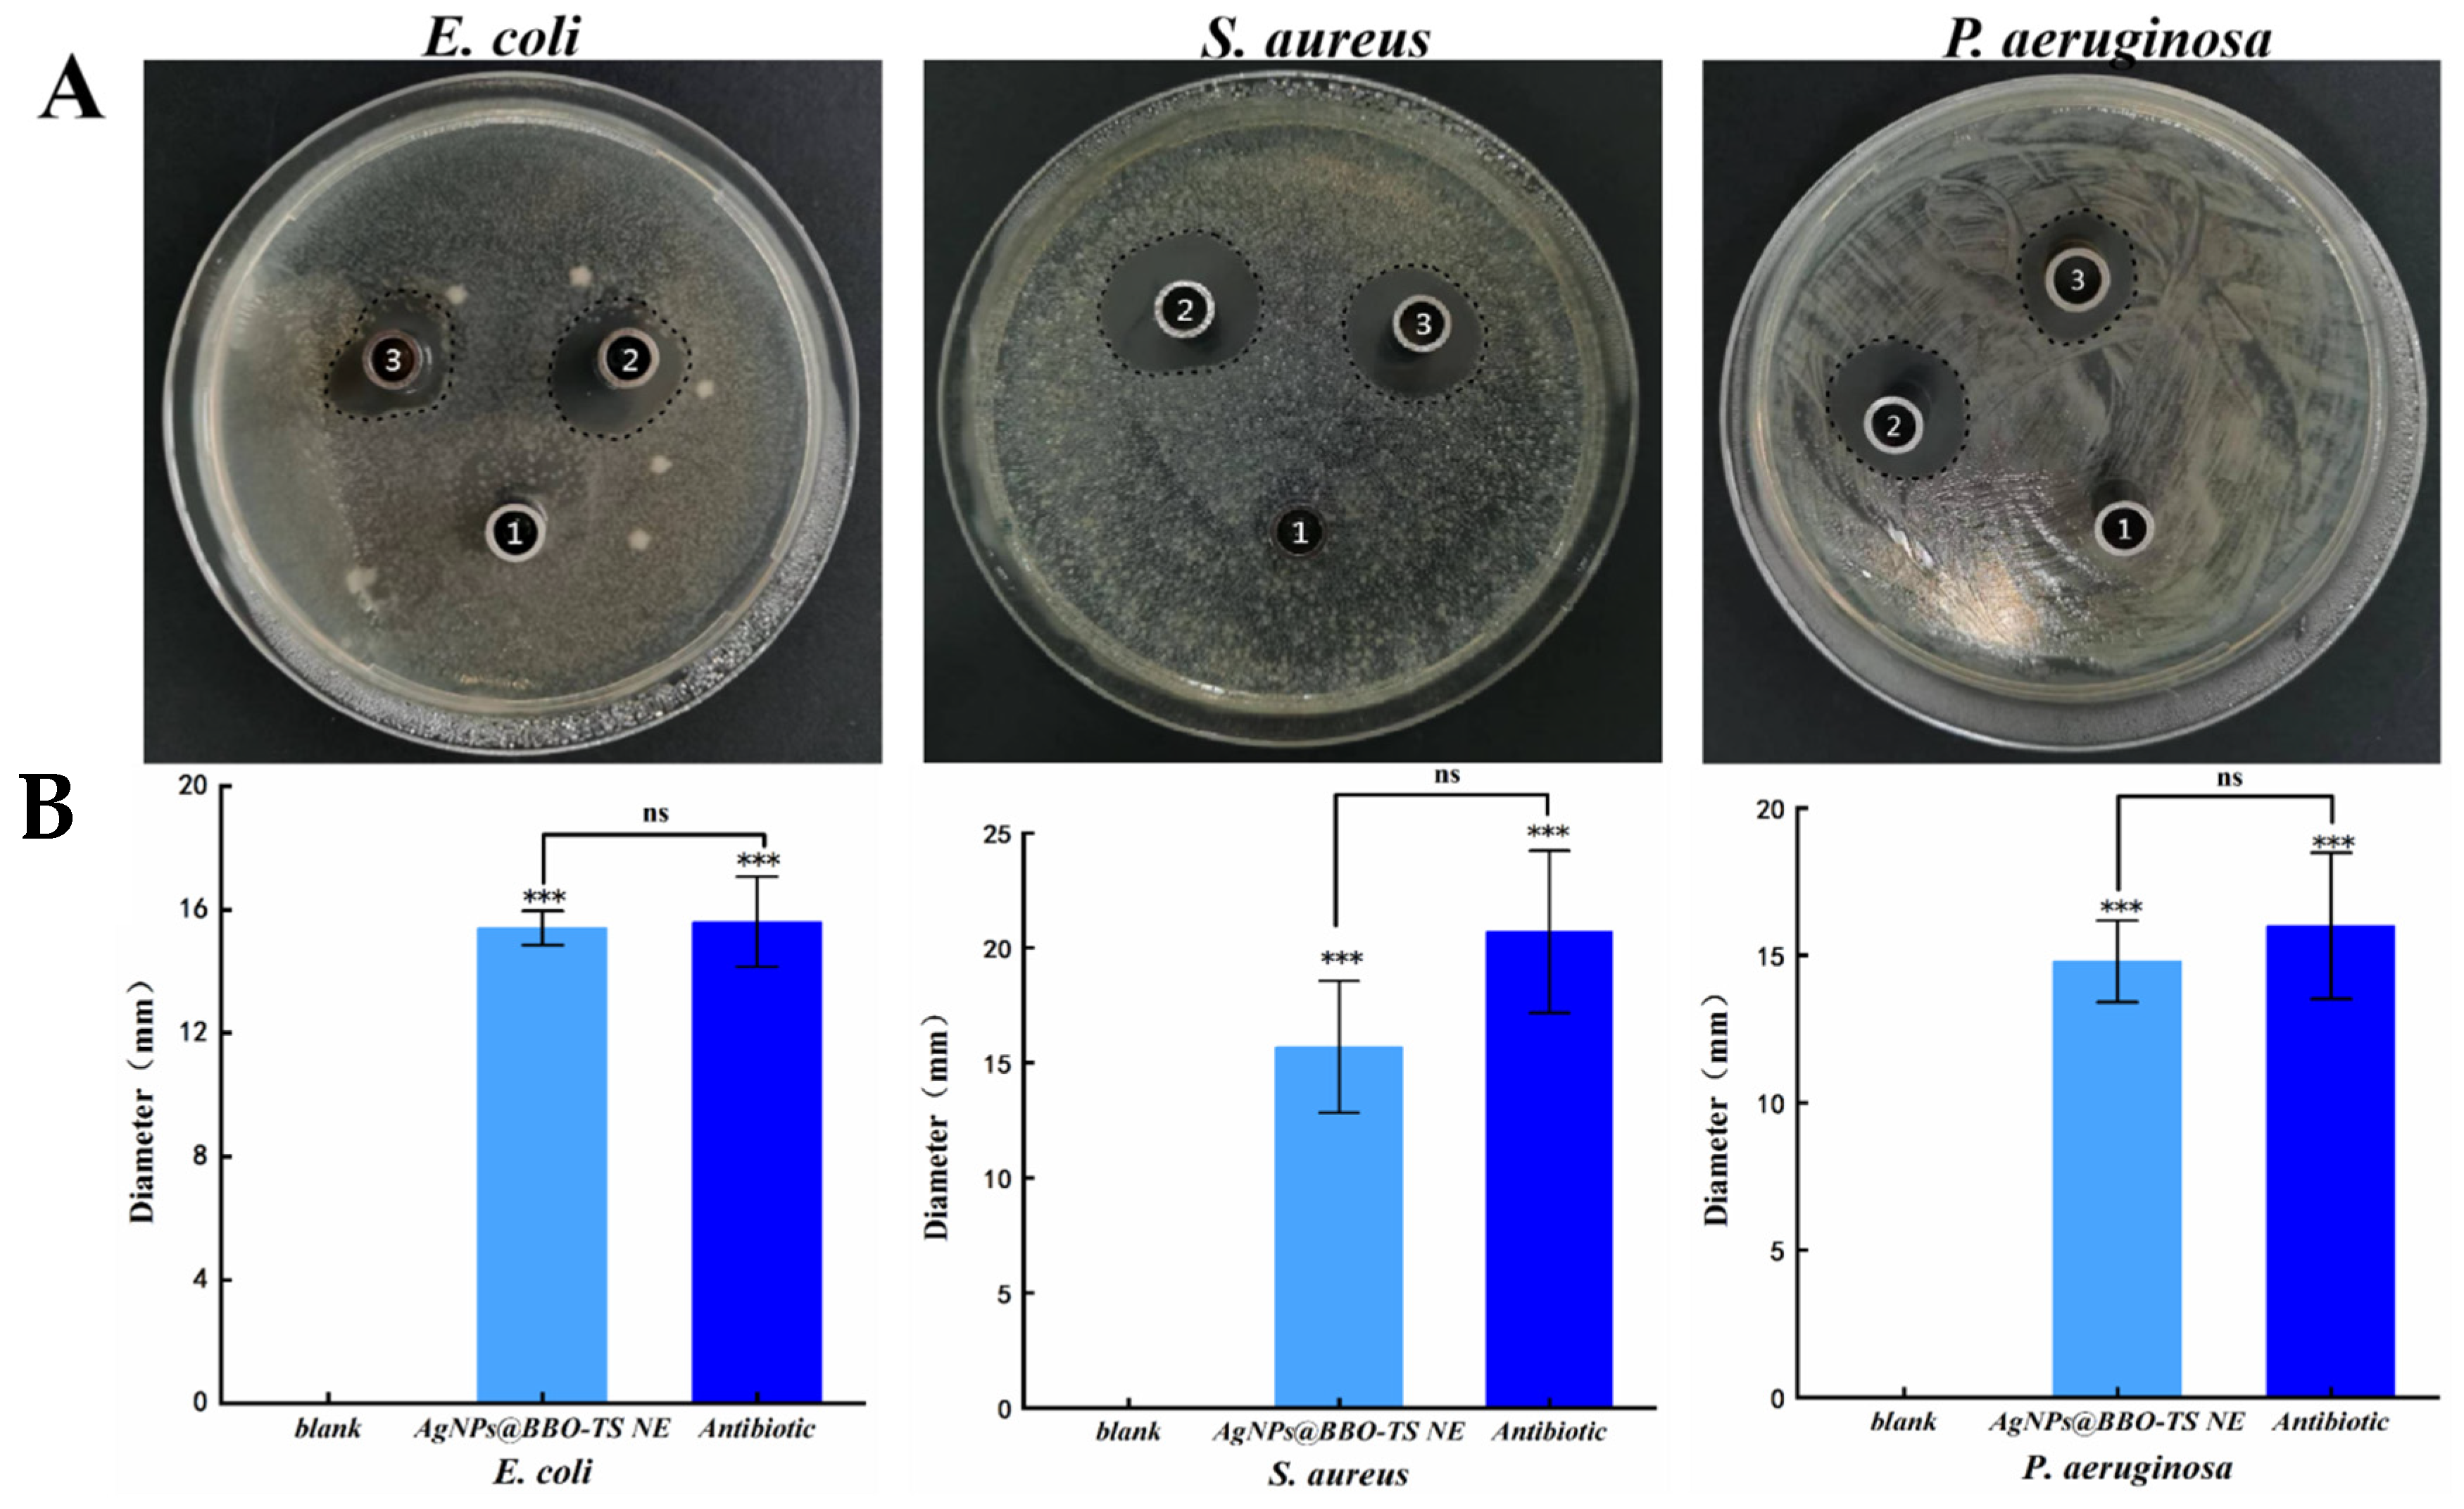
Molecules 29 02009 g008
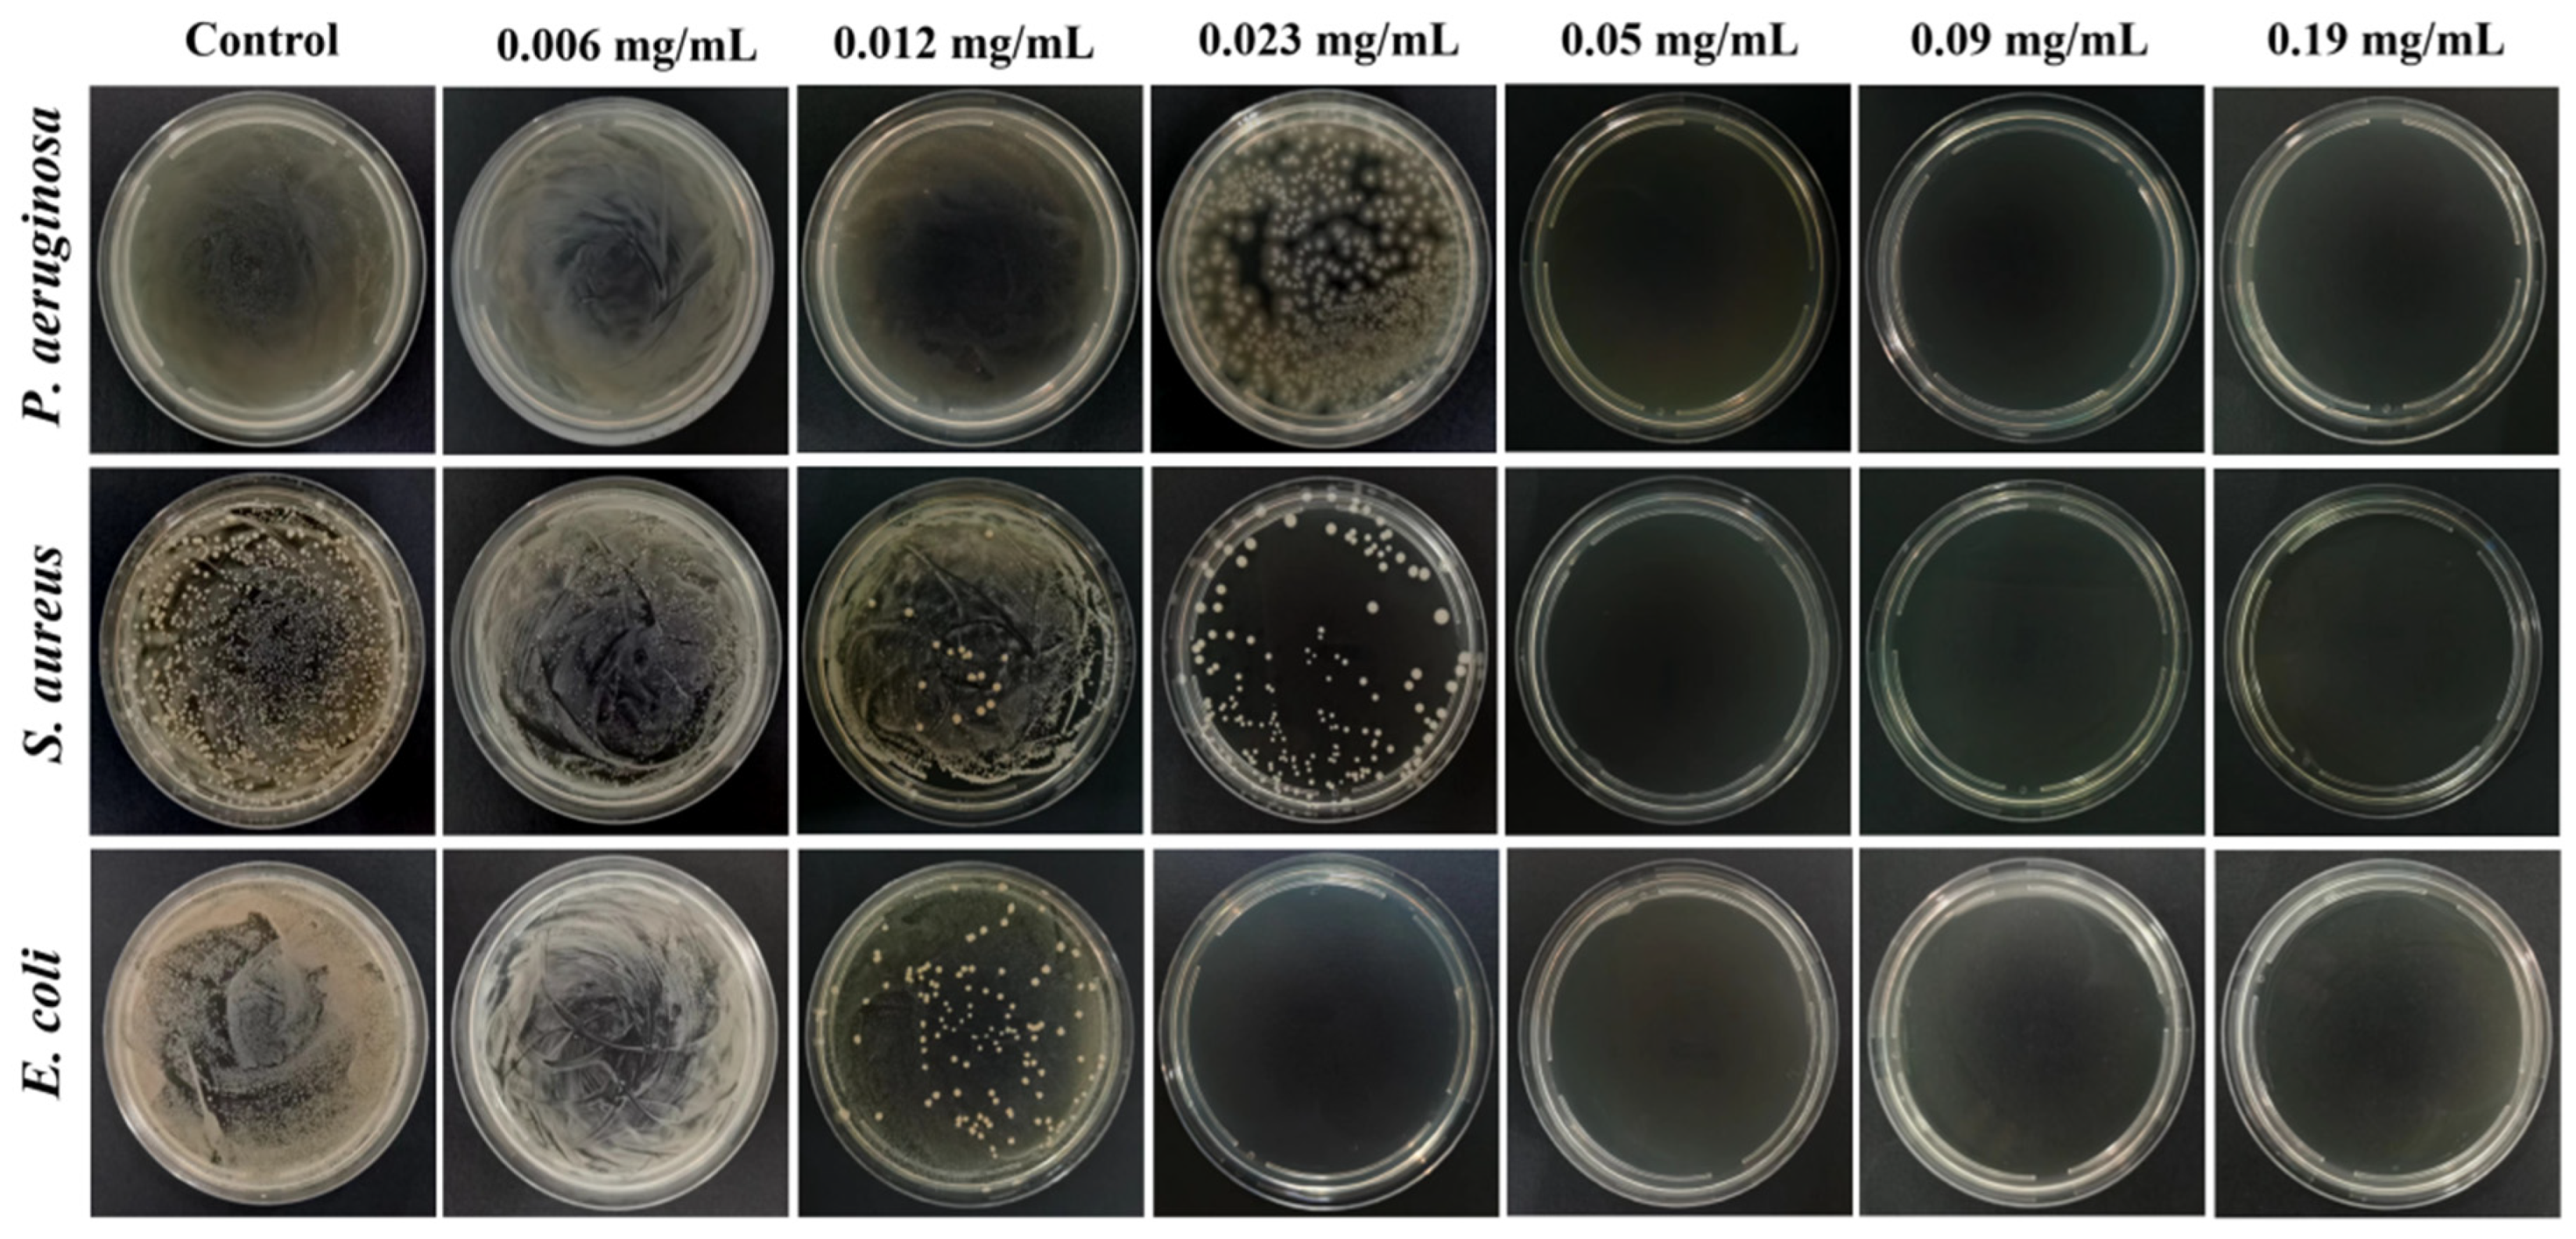
Molecules 29 02009 g009

Green Preparation and Antibacterial Activity Evaluation of AgNPs-Blumea balsamifera Oil Nanoemulsion
Abstract
1. Introduction
2. Results
2.1. Single-Factor Experiments to Optimize the Prescription of a BBO-TS NE
2.1.1. Effect of BBO Content
2.1.2. Effect of TS Concentration
2.1.3. Influence of Ultrasonic Power and Ultrasonic Time
2.2. The Existing Form of Silver in BBO-TS NE
2.3. AgNO3 Concentration
2.4. Characterization of the AgNPs@BBO-TS NE
2.4.1. Appearance and Type Analysis
2.4.2. Average Particle Size, PDI, Zeta Potential, and Size Distribution
2.4.3. Morphology, pH, and Turbidity
2.5. Stability Studies
2.6. Cytotoxicity
2.7. Antibacterial Activity Assay
2.7.1. Bacterial Inhibition Circle (BIC)
2.7.2. Minimum Inhibitory Concentration (MIC) and Minimum Bactericidal Concentration (MBC)
2.7.3. Growth Curve
2.7.4. Synergy Effect
3. Discussion
4. Materials and Methods
4.1. Strains and Media
4.2. Preparation of BBO-TS NE
4.3. Single-Factor Experiments to Optimize the Prescription of the BBO-TS NE
4.4. The Existing Form of Silver in the BBO-TS NE
4.5. Determination of the AgNO3 Concentration
4.6. Characterization of the AgNPs@BBO-TS NE
4.6.1. Appearance and Type Analysis
4.6.2. Average Particle Size, Zeta Potential, Particle Size Distribution, and PDI
4.6.3. Morphological Analysis
4.6.4. Determination of pH Value
4.6.5. Determination of Turbidity
4.7. Stability
4.8. Cytotoxicity
4.9. Antimicrobial Activity
4.9.1. Measurement of Bacterial Inhibition Circles
4.9.2. Minimum Inhibitory Concentration (MIC) and Minimum Bactericidal Concentration (MBC)
4.9.3. Growth Curve
4.9.4. Synergy Effect
4.10. Statistical Analysis
5. Conclusions
Supplementary Materials
Author Contributions
Funding
Institutional Review Board Statement
Informed Consent Statement
Data Availability Statement
Acknowledgments
Conflicts of Interest
References
- Casanova, J.L.; Abel, L. Lethal Infectious Diseases as Inborn Errors of Immunity: Toward a Synthesis of the Germ and Genetic Theories. Annu. Rev. Pathol. 2021, 16, 23–50. [Google Scholar] [CrossRef]
- Alos, J.I. [Antibiotic resistance: A global crisis]. Enferm. Infecc. Microbiol. Clin. 2015, 33, 692–699. [Google Scholar] [CrossRef] [PubMed]
- Baquero, F.; Martinez, J.L.; Lanza, V.F.; Rodriguez-Beltran, J.; Galan, J.C.; San Millan, A.; Canton, R.; Coque, T.M. Evolutionary Pathways and Trajectories in Antibiotic Resistance. Clin. Microbiol. Rev. 2021, 34, e0005019. [Google Scholar]
- Wang, Z.; Liu, X.; Duan, Y.; Huang, Y. Infection microenvironment-related antibacterial nanotherapeutic strategies. Biomaterials 2022, 280, 121249. [Google Scholar] [CrossRef]
- Falleh, H.; Ben Jemaa, M.; Saada, M.; Ksouri, R. Essential oils: A promising eco-friendly food preservative. Food Chem. 2020, 330, 127268. [Google Scholar] [CrossRef] [PubMed]
- Pang, Y.; Wang, D.; Fan, Z.; Chen, X.; Yu, F.; Hu, X.; Wang, K.; Yuan, L. Blumea balsamifera—A phytochemical and pharmacological review. Molecules 2014, 19, 9453–9477. [Google Scholar] [CrossRef] [PubMed]
- Widhiantara, I.G.; Jawi, I.M. Phytochemical composition and health properties of Sembung plant (Blumea balsamifera): A review. Vet. World. 2021, 14, 1185–1196. [Google Scholar] [CrossRef] [PubMed]
- Yang, H.; Gao, Y.; Long, L.; Cai, Y.; Liao, J.; Peng, J.; Wang, L. Antibacterial effect of Blumea balsamifera (L.) DC. essential oil against Staphylococcus aureus. Arch. Microbiol. 2021, 203, 3981–3988. [Google Scholar] [CrossRef]
- He, C.; Yang, P.; Wang, L.; Jiang, X.; Zhang, W.; Liang, X.; Yin, L.; Yin, Z.; Geng, Y.; Zhong, Z.; et al. Antibacterial effect of Blumea balsamifera DC. essential oil against Haemophilus parasuis. Arch. Microbiol. 2020, 202, 2499–2508. [Google Scholar] [CrossRef]
- He, Q.; Guo, M.; Jin, T.Z.; Arabi, S.A.; Liu, D. Ultrasound improves the decontamination effect of thyme essential oil nanoemulsions against Escherichia coli O157: H7 on cherry tomatoes. Int. J. Food Microbiol. 2021, 337, 108936. [Google Scholar] [CrossRef]
- Sneha, K.; Kumar, A. Nanoemulsions: Techniques for the preparation and the recent advances in their food applications. Innov. Food Sci. Emerg. 2022, 76, 102914. [Google Scholar]
- Guo, N.; Tong, T.; Ren, N.; Tu, Y.; Li, B. Saponins from seeds of Genus Camellia: Phytochemistry and bioactivity. Phytochemistry 2018, 149, 42–55. [Google Scholar] [CrossRef] [PubMed]
- McClements, D.J.; Das, A.K.; Dhar, P.; Nanda, P.K.; Chatterjee, N. Nanoemulsion-based technologies for delivering natural plant-based antimicrobials in foods. Front. Sustain. Food Syst. 2021, 5, 643208. [Google Scholar] [CrossRef]
- Rai, M.; Yadav, A.; Gade, A. Silver nanoparticles as a new generation of antimicrobials. Biotechnol. Adv. 2009, 27, 76–83. [Google Scholar] [CrossRef] [PubMed]
- Hu, D.; Ogawa, K.; Kajiyama, M.; Enomae, T. Characterization of self-assembled silver nanoparticle ink based on nanoemulsion method. R. Soc. Open Sci. 2020, 7, 200296. [Google Scholar] [CrossRef]
- Phan, K.S.; Nguyen, T.M.; To, X.T.; Le, T.T.H.; Nguyen, T.T.; Pham, K.D.; Hoang, P.H.; Dong, T.N.; Dang, D.K.; Phan, T.H.T.; et al. Allium sativum@AgNPs and Phyllanthus urinaria@AgNPs: A comparative analysis for antibacterial application. RSC Adv. 2022, 12, 35730–35743. [Google Scholar] [CrossRef]
- Nouri, Z.; Hajialyani, M.; Izadi, Z.; Bahramsoltani, R.; Farzaei, M.H.; Abdollahi, M. Nanophytomedicines for the Prevention of Metabolic Syndrome: A Pharmacological and Biopharmaceutical Review. Front. Bioeng. Biotechnol. 2020, 8, 425. [Google Scholar] [CrossRef] [PubMed]
- Yang, L.; Aguilar, Z.P.; Qu, F.; Xu, H.; Xu, H.; Wei, H. Enhanced antimicrobial activity of silver nanoparticles-Lonicera Japonica Thunb combo. IET Nanobiotechnol. 2016, 10, 28–32. [Google Scholar] [CrossRef] [PubMed]
- Sagesaka, Y.M.; Uemura, T.; Suzuki, Y.; Sugiura, T.; Yoshida, M.; Yamaguchi, K.; Kyuki, K. [Antimicrobial and anti-inflammatory actions of tea-leaf saponin]. Yakugaku Zasshi 1996, 116, 238–243. [Google Scholar] [CrossRef]
- Sur, P.; Chaudhuri, T.; Vedasiromoni, J.R.; Gomes, A.; Ganguly, D.K. Antiinflammatory and antioxidant property of saponins of tea [Camellia sinensis (L) O. Kuntze] root extract. Phytother. Res. 2001, 15, 174–176. [Google Scholar] [CrossRef]
- Jiang, Z.L.; Zhou, Y.; Ge, W.C.; Yuan, K. Phytochemical compositions of volatile oil from Blumea balsamifera and their biological activities. Pharmacogn. Mag. 2014, 10, 346–352. [Google Scholar] [CrossRef] [PubMed]
- Singh, Y.; Meher, J.G.; Raval, K.; Khan, F.A.; Chaurasia, M.; Jain, N.K.; Chourasia, M.K. Nanoemulsion: Concepts, development and applications in drug delivery. J. Control. Release 2017, 252, 28–49. [Google Scholar] [CrossRef] [PubMed]
- Long, J.; Song, J.; Zhang, X.; Deng, M.; Xie, L.; Zhang, L.; Li, X. Tea saponins as natural stabilizers for the production of hesperidin nanosuspensions. Int. J. Pharm. 2020, 583, 119406. [Google Scholar] [CrossRef]
- Yu, X.L.; He, Y. Tea saponins: Effective natural surfactants beneficial for soil remediation, from preparation to application. RSC Adv. 2018, 8, 24312–24321. [Google Scholar] [CrossRef] [PubMed]
- Tayeb, H.H.; Sainsbury, F. Nanoemulsions in drug delivery: Formulation to medical application. Nanomedicine 2018, 13, 2507–2525. [Google Scholar] [CrossRef] [PubMed]
- Song, R.; Yan, F.; Cheng, M.; Dong, F.; Lin, Y.; Wang, Y.; Song, B. Ultrasound-Assisted Preparation of Exopolysaccharide/Nystatin Nanoemulsion for Treatment of Vulvovaginal Candidiasis. Int. J. Nanomed. 2020, 15, 2027–2044. [Google Scholar] [CrossRef] [PubMed]
- Feng, D.; Zhang, R.; Zhang, M.; Fang, A.; Shi, F. Synthesis of Eco-Friendly Silver Nanoparticles Using Glycyrrhizin and Evaluation of Their Antibacterial Ability. Nanomaterials 2022, 12, 2636. [Google Scholar] [CrossRef] [PubMed]
- Huemer, M.; Mairpady Shambat, S.; Brugger, S.D.; Zinkernagel, A.S. Antibiotic resistance and persistence-Implications for human health and treatment perspectives. EMBO Rep. 2020, 21, e51034. [Google Scholar] [CrossRef] [PubMed]
- Suganya, T.; Packiavathy, I.; Aseervatham, G.S.B.; Carmona, A.; Rashmi, V.; Mariappan, S.; Devi, N.R.; Ananth, D.A. Tackling Multiple-Drug-Resistant Bacteria With Conventional and Complex Phytochemicals. Front. Cell Infect. Microbiol. 2022, 12, 883839. [Google Scholar] [CrossRef]
- Natan, M.; Banin, E. From Nano to Micro: Using nanotechnology to combat microorganisms and their multidrug resistance. FEMS Microbiol. Rev. 2017, 41, 302–322. [Google Scholar] [CrossRef]
- Hobman, J.L.; Crossman, L.C. Bacterial antimicrobial metal ion resistance. J. Med. Microbiol. 2015, 64, 471–497. [Google Scholar] [CrossRef] [PubMed]
- Liu, Q.; Gao, Y.; Fu, X.; Chen, W.; Yang, J.; Chen, Z.; Wang, Z.; Zhuansun, X.; Feng, J.; Chen, Y. Preparation of peppermint oil nanoemulsions: Investigation of stability, antibacterial mechanism and apoptosis effects. Colloids Surf. B 2021, 201, 111626. [Google Scholar] [CrossRef] [PubMed]
- Bernardes, W.A.; Lucarini, R.; Tozatti, M.G.; Flauzino, L.G.; Souza, M.G.; Turatti, I.C.; Andrade e Silva, M.L.; Martins, C.H.; da Silva Filho, A.A.; Cunha, W.R. Antibacterial activity of the essential oil from Rosmarinus officinalis and its major components against oral pathogens. Z. Naturforsch. C. J. Biosci. 2010, 65, 588–593. [Google Scholar] [CrossRef] [PubMed]
- Pongsumpun, P.; Iwamoto, S.; Siripatrawan, U. Response surface methodology for optimization of cinnamon essential oil nanoemulsion with improved stability and antifungal activity. Ultrason. Sonochem. 2020, 60, 104604. [Google Scholar] [CrossRef]
- Chouhan, S.; Sharma, K.; Guleria, S. Antimicrobial Activity of Some Essential Oils-Present Status and Future Perspectives. Medicines 2017, 4, 58. [Google Scholar] [CrossRef] [PubMed]
- Saffarionpour, S. Preparation of food flavor nanoemulsions by high-and low-energy emulsification approaches. Food Eng. Rev. 2019, 11, 259–289. [Google Scholar] [CrossRef]
- Liu, Q.; Huang, H.; Chen, H.; Lin, J.; Wang, Q. Food-Grade Nanoemulsions: Preparation, Stability and Application in Encapsulation of Bioactive Compounds. Molecules 2019, 24, 4242. [Google Scholar] [CrossRef]
- Silva, H.D.; Cerqueira, M.Â.; Vicente, A.A. Erratum to: Nanoemulsions for Food Applications: Development and Characterization. Food Bioprocess Tech. 2014, 7, 854–867. [Google Scholar] [CrossRef]
- Krishnamoorthy, R.; Athinarayanan, J.; Periasamy, V.S.; Adisa, A.R.; Al-Shuniaber, M.A.; Gassem, M.A.; Alshatwi, A.A. Antimicrobial activity of nanoemulsion on drug-resistant bacterial pathogens. Microb. Pathog. 2018, 120, 85–96. [Google Scholar] [CrossRef]
- Najafi-Taher, R.; Ghaemi, B.; Kharrazi, S.; Rasoulikoohi, S.; Amani, A. Promising Antibacterial Effects of Silver Nanoparticle-Loaded Tea Tree Oil Nanoemulsion: A Synergistic Combination Against Resistance Threat. AAPS PharmSciTech 2018, 19, 1133–1340. [Google Scholar] [CrossRef]
- Li, Q.; Zhong, H.; Cao, Y. Effective extraction and recovery of rare earth elements (REEs) in contaminated soils using a reusable biosurfactant. Chemosphere 2020, 256, 127070. [Google Scholar] [CrossRef] [PubMed]
- Nanda, N.; Ranjani, S.; Hemalatha, S. Comparative Study of Effects of Endophytic Fungal Silver Nanoparticles and Nanoemulsion on Escherichia coli. Appl. Biochem. Biotechnol. 2023, 195, 4237–4250. [Google Scholar] [CrossRef]
- Choi, S.J.; McClements, D.J. Nanoemulsions as delivery systems for lipophilic nutraceuticals: Strategies for improving their formulation, stability, functionality and bioavailability. Food Sci. Biotechnol. 2020, 29, 149–168. [Google Scholar] [CrossRef]
- Shamsara, O.; Jafari, S.M.; Muhidinov, Z.K. Fabrication, characterization and stability of oil in water nano-emulsions produced by apricot gum-pectin complexes. Int. J. Biol. Macromol. 2017, 103, 1285–1293. [Google Scholar] [CrossRef]
- Li, M.; Bi, D.; Yao, L.; Yi, J.; Fang, W.; Wu, Y.; Xu, H.; Hu, Z.; Xu, X. Optimization of preparation conditions and in vitro sustained-release evaluation of a novel nanoemulsion encapsulating unsaturated guluronate oligosaccharide. Carbohydr. Polym. 2021, 264, 118047. [Google Scholar] [CrossRef] [PubMed]
- Muniyan, A.; Ravi, K.; Mohan, U.; Panchamoorthy, R. Characterization and in vitro antibacterial activity of saponin-conjugated silver nanoparticles against bacteria that cause burn wound infection. World J. Microbiol. Biotechnol. 2017, 33, 147. [Google Scholar] [CrossRef] [PubMed]
- Gavade, N.L.; Kadam, A.N.; Suwarnkar, M.B.; Ghodake, V.P.; Garadkar, K.M. Biogenic synthesis of multi-applicative silver nanoparticles by using Ziziphus Jujuba leaf extract. Spectrochim. Acta A Mol. Biomol. Spectrosc. 2015, 136 Pt B, 953–960. [Google Scholar] [CrossRef]
- Manosalva, N.; Tortella, G.; Cristina, D.M.; Schalchli, H.; Seabra, A.B.; Durán, N.; Rubilar, O. Green synthesis of silver nanoparticles: Effect of synthesis reaction parameters on antimicrobial activity. World J. Microbiol. Biotechnol. 2019, 35, 88. [Google Scholar] [CrossRef]
- Haidari, H.; Kopecki, Z.; Bright, R.; Cowin, A.J.; Garg, S.; Goswami, N.; Vasilev, K. Ultrasmall AgNP-Impregnated Biocompatible Hydrogel with Highly Effective Biofilm Elimination Properties. ACS Appl. Mater Interfaces 2020, 12, 41011–41025. [Google Scholar] [CrossRef]
- Tang, S.; Zheng, J. Antibacterial Activity of Silver Nanoparticles: Structural Effects. Adv. Healthc. Mater. 2018, 7, e1701503. [Google Scholar] [CrossRef]
- Zaidi, S.; Misba, L.; Khan, A.U. Nano-therapeutics: A revolution in infection control in post antibiotic era. Nanomedicine 2017, 13, 2281–2301. [Google Scholar] [CrossRef] [PubMed]
- Mutlu-Ingok, A.; Devecioglu, D.; Dikmetas, D.N.; Karbancioglu-Guler, F.; Capanoglu, E. Antibacterial, Antifungal, Antimycotoxigenic, and Antioxidant Activities of Essential Oils: An Updated Review. Molecules 2020, 25, 4711. [Google Scholar] [CrossRef] [PubMed]
- Pelgrift, R.Y.; Friedman, A.J. Nanotechnology as a therapeutic tool to combat microbial resistance. Adv. Drug Deliv. Rev. 2013, 65, 1803–1815. [Google Scholar] [CrossRef] [PubMed]
- Reichling, J.; Schnitzler, P.; Suschke, U.; Saller, R. Essential oils of aromatic plants with antibacterial, antifungal, antiviral, and cytotoxic properties—An overview. Forsch. Komplementmed. 2009, 16, 79–90. [Google Scholar] [CrossRef] [PubMed]
- Rao, J.; Chen, B.; McClements, D.J. Improving the Efficacy of Essential Oils as Antimicrobials in Foods: Mechanisms of Action. Annu. Rev. Food Sci. Technol. 2019, 10, 365–387. [Google Scholar] [CrossRef] [PubMed]
- Chatterjee, T.; Chatterjee, B.K.; Majumdar, D.; Chakrabarti, P. Antibacterial effect of silver nanoparticles and the modeling of bacterial growth kinetics using a modified Gompertz model. Biochim. Biophys. Acta 2015, 1850, 299–306. [Google Scholar] [CrossRef] [PubMed]
- Frei, A.; Verderosa, A.D.; Elliott, A.G.; Zuegg, J.; Blaskovich, M.A.T. Metals to combat antimicrobial resistance. Nat. Rev. Chem. 2023, 7, 202–224. [Google Scholar] [CrossRef] [PubMed]
- Ghosh, V.; Saranya, S.; Mukherjee, A.; Chandrasekaran, N. Cinnamon oil nanoemulsion formulation by ultrasonic emulsification: Investigation of its bactericidal activity. J. Nanosci. Nanotechnol. 2013, 13, 114–122. [Google Scholar] [CrossRef] [PubMed]
- Zhang, J.; Liu, Z.; Tao, C.; Lin, X.; Zhang, M.; Zeng, L.; Chen, X.; Song, H. Cationic nanoemulsions with prolonged retention time as promising carriers for ophthalmic delivery of tacrolimus. Eur. J. Pharm. Sci. 2020, 144, 105229. [Google Scholar] [CrossRef]
- Nagaraju, P.G.; Sindhu, P.; Dubey, T.; Chinnathambi, S.; CG, P.P.; Rao, P.J. Influence of sodium caseinate, maltodextrin, pectin and their Maillard conjugate on the stability, in vitro release, anti-oxidant property and cell viability of eugenol-olive oil nanoemulsions. Int. J. Biol. Macromol. 2021, 183, 158–170. [Google Scholar] [CrossRef]
- Wang, L.; Li, Y.; Xiang, D.; Zhang, W.; Bai, X. Stability of lutein in O/W emulsion prepared using xanthan and propylene glycol alginate. Int. J. Biol. Macromol. 2020, 152, 371–379. [Google Scholar] [CrossRef]
- Wang, W.; Wang, R.; Yao, J.; Luo, S.; Wang, X.; Zhang, N.; Wang, L.; Zhu, X. Effect of ultrasonic power on the emulsion stability of rice bran protein-chlorogenic acid emulsion. Ultrason. Sonochem. 2022, 84, 105959. [Google Scholar] [CrossRef] [PubMed]
- Zhu, Y.; Chen, T.; Feng, T.; Zhang, J.; Meng, Z.; Zhang, N.; Luo, G.; Wang, Z.; Pang, Y.; Zhou, Y. Fabrication and Biological Activities of All-in-One Composite Nanoemulsion Based on Blumea balsamifera Oil-Tea Tree Oil. Molecules 2023, 28, 5889. [Google Scholar] [CrossRef] [PubMed]
- Kaewsaneha, C.; Jangpatarapongsa, K.; Tangchaikeeree, T.; Polpanich, D.; Tangboriboonrat, P. Fluorescent chitosan functionalized magnetic polymeric nanoparticles: Cytotoxicity and in vitro evaluation of cellular uptake. J. Biomater. Appl. 2014, 29, 761–768. [Google Scholar] [CrossRef] [PubMed]
- Han, B.; Yu, B.; Liu, L.; Xiu, Y.; Wang, H. Experimental investigation of the strong stability, antibacterial and anti-inflammatory effect and high bioabsorbability of a perilla oil or linseed oil nanoemulsion system. RSC Adv. 2019, 9, 25739–25749. [Google Scholar] [CrossRef]
- Long, Y.; Huang, W.; Wang, Q.; Yang, G. Green synthesis of garlic oil nanoemulsion using ultrasonication technique and its mechanism of antifungal action against Penicillium italicum. Ultrason Sonochem. 2020, 64, 104970. [Google Scholar] [CrossRef]
- Luo, F.; Zeng, D.; Chen, R.; Zafar, A.; Weng, L.; Wang, W.; Tian, Y.; Hasan, M.; Shu, X. PEGylated dihydromyricetin-loaded nanoliposomes coated with tea saponin inhibit bacterial oxidative respiration and energy metabolism. Food Funct. 2021, 12, 9007–9017. [Google Scholar] [CrossRef]
- Feng, X.; Feng, K.; Zheng, Q.; Tan, W.; Zhong, W.; Liao, C.; Liu, Y.; Li, S.; Hu, W. Preparation and characterization of geraniol nanoemulsions and its antibacterial activity. Front. Microbiol. 2022, 13, 1080300. [Google Scholar]
- Bano, I.; Ghauri, M.A.; Yasin, T.; Huang, Q.; Palaparthi, A.D. Characterization and potential applications of gamma irradiated chitosan and its blends with poly(vinyl alcohol). Int. J. Biol. Macromol. 2014, 65, 81–88. [Google Scholar] [CrossRef]

| Sample | Particle Size (nm) | PDI | Zeta Potential (mV) |
|---|---|---|---|
| AgNPs@BBO-TS NE | 249.47 ± 6.23 | 0.239 ± 0.003 | −35.82 ± 4.26 |
| Batch Number | A0 | A1 | K |
|---|---|---|---|
| 1 | 0.511 ± 0.040 | 0.469 ± 0.001 | 91.8% |
| 2 | 0.458 ± 0.002 | 0.437 ± 0.001 | 95.6% |
| 3 | 0.502 ± 0.002 | 0.471 ± 0.001 | 93.8% |
| Culture | MIC (mg/mL) | MBC (mg/mL) |
|---|---|---|
| E. coli | 0.012 | 0.023 |
| S. aureus | 0.023 | 0.05 |
| P. aeruginosa | 0.023 | 0.05 |
| Group Number | E. coli | S. aureus | P. aeruginosa |
|---|---|---|---|
| MIC | 0.07 ± 0.010 b | 0.07 ± 0.003 b | 0.07 ± 0.004 b |
| Negative | 0.05 ± 0.002 b | 0.06 ± 0.003 b | 0.07 ± 0.006 b |
| Positive | 0.46 ± 0.021 a | 0.37 ± 0.019 a | 1.04 ± 0.011 a |
| Group Number | Strain | Bacteriostatic Ring Diameter (mm) | |||
|---|---|---|---|---|---|
| AgNPs@BBO-TS NE | AgNPs-TS | BBO-TS/BBO | Normal Saline | ||
| BBO-TS (1%) | E. coli | 14.1 ± 0.63 | 13.3 ± 0.47 | —— | —— |
| S. aureus | 17.7 ± 1.00 | 17.3 ± 0.24 | —— | —— | |
| P. aeruginosa | 17.0 ± 0.82 | 16.5 ± 0.39 | —— | —— | |
| BBO (10 μL) | E. coli | 19.4 ± 0.81 | 18.8 ± 0.49 | 10.4 ± 0.13 | —— |
| S. aureus | 20.6 ± 0.71 | 18.2 ± 0.47 | 11.3 ± 0.48 | —— | |
| P. aeruginosa | 17.3 ± 0.92 | 16.0 ± 0.70 | 8.2 ± 0.30 | —— | |
Disclaimer/Publisher’s Note: The statements, opinions and data contained in all publications are solely those of the individual author(s) and contributor(s) and not of MDPI and/or the editor(s). MDPI and/or the editor(s) disclaim responsibility for any injury to people or property resulting from any ideas, methods, instructions or products referred to in the content. |
© 2024 by the authors. Licensee MDPI, Basel, Switzerland. This article is an open access article distributed under the terms and conditions of the Creative Commons Attribution (CC BY) license (https://creativecommons.org/licenses/by/4.0/).
Share and Cite
Ma, C.; Liu, B.; Du, L.; Liu, W.; Zhu, Y.; Chen, T.; Wang, Z.; Chen, H.; Pang, Y. Green Preparation and Antibacterial Activity Evaluation of AgNPs-Blumea balsamifera Oil Nanoemulsion. Molecules 2024, 29, 2009. https://doi.org/10.3390/molecules29092009
Ma C, Liu B, Du L, Liu W, Zhu Y, Chen T, Wang Z, Chen H, Pang Y. Green Preparation and Antibacterial Activity Evaluation of AgNPs-Blumea balsamifera Oil Nanoemulsion. Molecules. 2024; 29(9):2009. https://doi.org/10.3390/molecules29092009
Chicago/Turabian StyleMa, Chunfang, Bingnan Liu, Lingfeng Du, Wei Liu, Yue Zhu, Teng Chen, Zuhua Wang, Hongpeng Chen, and Yuxin Pang. 2024. "Green Preparation and Antibacterial Activity Evaluation of AgNPs-Blumea balsamifera Oil Nanoemulsion" Molecules 29, no. 9: 2009. https://doi.org/10.3390/molecules29092009
APA StyleMa, C., Liu, B., Du, L., Liu, W., Zhu, Y., Chen, T., Wang, Z., Chen, H., & Pang, Y. (2024). Green Preparation and Antibacterial Activity Evaluation of AgNPs-Blumea balsamifera Oil Nanoemulsion. Molecules, 29(9), 2009. https://doi.org/10.3390/molecules29092009

